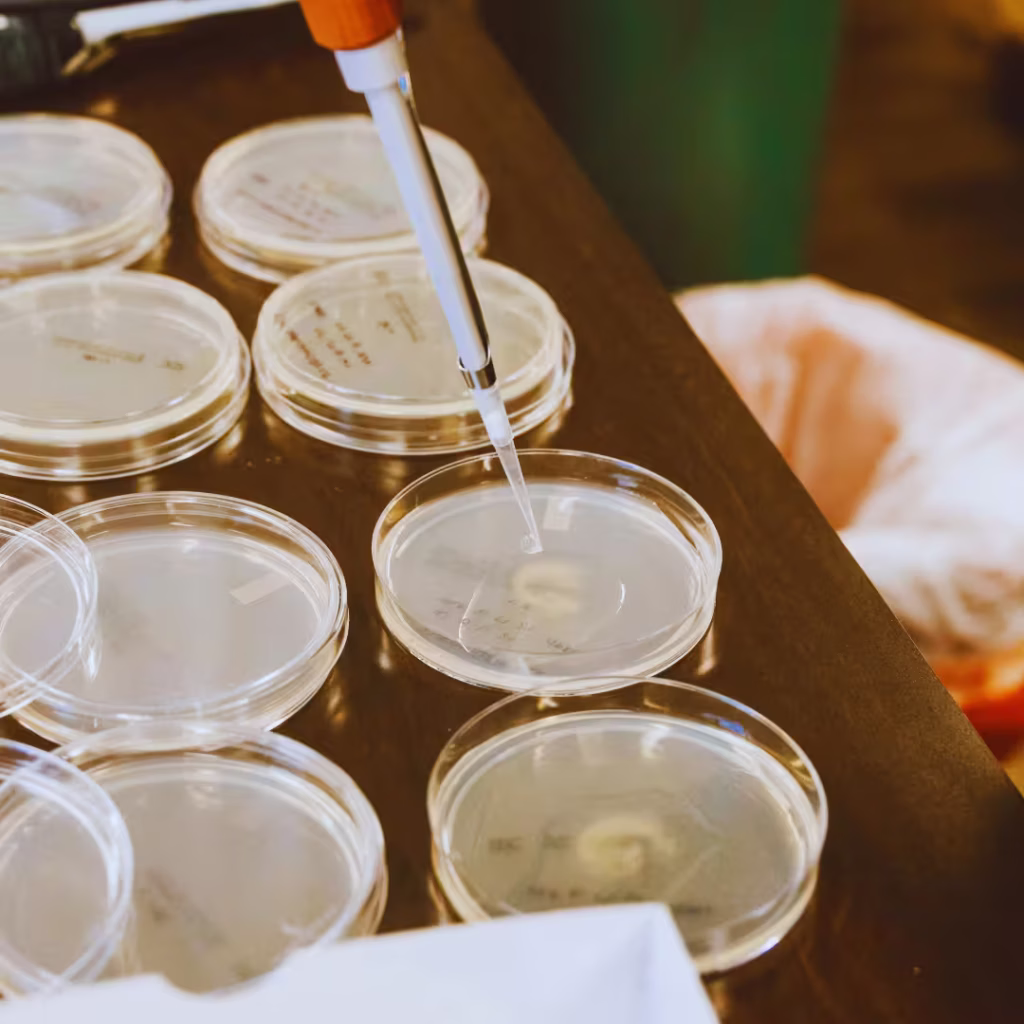

Eu sei exatamente como é a sua rotina. Eu já estive lá, no plantão das 19h às 07h, sentindo o peso do cansaço nas pernas e a responsabilidade de vidas humanas em cada decisão. Você acorda, veste seu branco, prepara o café rápido e sai com uma missão nobre: cuidar. Mas já parou para pensar em quem cuida de você quando as coisas dão errado? O acidente de trabalho na enfermagem não é apenas um registro burocrático em um formulário da empresa; é um evento que pode mudar o curso da sua vida profissional e pessoal para sempre. Se você acha que um “furinho” de agulha é só um detalhe ou que aquele estresse esmagador é “fase do hospital”, eu preciso te revelar uma coisa: você pode estar sentado em cima de uma mina terrestre jurídica e de saúde.
Fica comigo até o final deste texto, porque o que eu vou te revelar aqui é um verdadeiro jogo de atenção. Vou te mostrar os segredos que os hospitais muitas vezes escondem, os direitos que o INSS não te conta de bandeja e como você pode usar estratégias de proteção para garantir que, aconteça o que acontecer, você e sua família não fiquem desamparados. Vamos mergulhar fundo no universo do acidente de trabalho na enfermagem e transformar a sua visão sobre segurança e legislação.
O cenário invisível: A realidade dos números em 2024 e 2025
Você pode pensar que os acidentes são raros, mas os dados de 2024 e do primeiro semestre de 2025 pintam um quadro alarmante. O Brasil registrou mais de 1,6 mil mortes por acidentes de trabalho apenas na primeira metade deste ano. E adivinha qual setor está no topo das notificações? Sim, a nossa área da saúde. Em 2022, o setor concentrou 10% de todas as notificações do INSS, e a maioria dessas vítimas eram técnicos de enfermagem e enfermeiros.
Esses números não são apenas estatísticas frias. Eles representam colegas que, como você, estavam apenas fazendo o seu trabalho. O Observatório de Segurança e Saúde no Trabalho registrou mais de 8,8 milhões de notificações entre 2012 e 2024. Mas o que eu quero que você entenda é o efeito dominó: um acidente gera afastamento, o afastamento gera perda de renda, e a perda de renda gera um abalo emocional que pode levar ao Burnout. E por falar em mente, você sabia que só no ano passado mais de 470 mil pessoas se afastaram por saúde mental no Brasil?.
Panorama estatístico do setor saúde e segurança
| Indicador | Dado Recente | Impacto no Profissional |
| Mortes laborais (1º sem/2025) | +1.600 casos | Perda irreparável e luto institucional |
| Notificações totais (2012-2024) | 8,8 milhões | Exposição crônica ao risco |
| Participação do setor saúde (2022) | 10% das CATs | Concentração de risco em técnicos e enfermeiros |
| Afastamentos por saúde mental (2024) | 470.000 pessoas | Epidemia silenciosa de ansiedade e depressão |
| Custo previdenciário (2018-2022) | R$ 54 bilhões | Pressão econômica sobre o sistema público |
O segredo da NR-32: Sua armadura legal contra riscos
Se você trabalha na saúde, a NR-32 deveria ser sua leitura de cabeceira. Ela não é apenas um PDF chato do Ministério do Trabalho; é a norma que obriga o hospital a te dar segurança. Ela estabelece diretrizes para proteger você contra agentes biológicos, químicos e físicos. Sabe aquele descarte de perfurocortante que vive cheio? Ou aquela falta de luvas de qualidade? Isso é violação direta da NR-32.
A norma classifica os riscos biológicos em classes de 1 a 4. Quando você lida com um paciente com suspeita de tuberculose ou Ebola, o hospital tem o dever legal de seguir protocolos de contenção rigorosos. Se o hospital falha na aplicação da NR-32, ele não está apenas sendo “desorganizado”, ele está cometendo um ato ilícito que gera direito a indenizações pesadas.

Classes de risco biológico: Entenda onde você pisa
Eu preparei essa tabela para você nunca mais ter dúvida sobre o perigo que enfrenta em cada ala do hospital.
| Classe de Risco | Potencial de Dano | Exemplo de Agente | Medida de Proteção (NR-32) |
| Classe 1 | Baixo risco individual e comunitário | Bacillus subtilis | Higiene básica e boas práticas |
| Classe 2 | Moderado individual; baixo comunitário | Vírus da Febre Amarela | EPIs padrão e descarte correto |
| Classe 3 | Alto individual; limitado comunitário | Mycobacterium tuberculosis | Isolamento e proteção respiratória N95 |
| Classe 4 | Elevado risco individual e comunitário | Vírus Ebola / Marburg | Contenção máxima e protocolos rigorosos |
O perigo dos perfurocortantes: Mais que um pequeno susto
Vamos falar a real? O acidente com material perfurocortante é o pesadelo de todo enfermeiro. É aquele segundo de distração ou a pressa de um plantão caótico que resulta em uma agulha contaminada espetando seu dedo. A ciência é clara: esses acidentes são os maiores responsáveis pela transmissão de patógenos graves como HIV e Hepatites.
Muitas vezes, a culpa não é sua. A sobrecarga de trabalho, a falta de dispositivos de segurança e o cansaço extremo são os verdadeiros vilões. Se o seu hospital ainda usa seringas sem dispositivo de segurança (aquela capinha que trava a agulha), eles estão aumentando deliberadamente o seu risco de sofrer um acidente de trabalho na enfermagem. E o pior: se você se contamina e o hospital não emitiu a CAT, como você prova o nexo causal depois de 5 anos, quando a doença se manifestar?
O que fazer IMEDIATAMENTE após um acidente com perfurocortante
Se aconteceu agora, pare tudo e siga este roteiro. Não negligencie nenhum passo, pois cada minuto conta para a eficácia da medicação.
- Lave a área: Use água e sabão abundantemente. Não esprema a ferida, pois isso pode aumentar a área de contato do sangue com o tecido lesionado.
- Notifique a chefia: Não tenha medo de represálias. A notificação é um direito seu e uma obrigação da empresa.
- Identifique o paciente-fonte: Se possível, realize o teste rápido nele (com consentimento). Isso define se você precisará tomar os coquetéis.
- Inicie a PEP (Profilaxia Pós-Exposição): O tempo de ouro é de até 2 horas após o acidente, podendo chegar a 72 horas. Depois disso, a eficácia cai drasticamente.
- Exija a emissão da CAT: O hospital tem 24 horas para fazer isso. Se não fizerem, procure o seu sindicato imediatamente.
📩 Advogado trabalhista em Recife
Saúde mental: A ferida que não sangra, mas afasta
Eu preciso ter uma conversa séria com você sobre o Burnout. Na enfermagem, a carga emocional é devastadora. Você lida com a dor, a morte e famílias desesperadas. Isso gera um estresse crônico que, se não gerenciado, vira uma doença ocupacional.
O estresse ocupacional afeta 60% dos enfermeiros, e metade da categoria já apresenta sinais de Burnout. Sabe aquela sensação de que você não é mais capaz, ou aquele cinismo ao tratar o paciente como “o leito 10”? Isso é despersonalização, um sintoma clássico do esgotamento. E aqui vai o “pulo do gato”: o Burnout provocado pelo ambiente hospitalar também é considerado um acidente de trabalho na enfermagem por equiparação (doença do trabalho). Você tem direito a afastamento remunerado e estabilidade se provar que o hospital te adoeceu.
Diferenças cruciais: Estresse Comum vs. Burnout Ocupacional
| Sintoma | Estresse Comum | Síndrome de Burnout |
| Origem | Pressão pontual (ex: um dia difícil) | Crônico e relacionado apenas ao trabalho |
| Recuperação | Melhora com descanso e férias | O cansaço persiste mesmo após folgas |
| Atitude | Ansiedade e urgência | Cinismo e despersonalização |
| Impacto | Físico e momentâneo | Perda do sentido de realização pessoal |
Seus direitos de ouro: CAT, B91 e a Pensão Vitalícia
Agora entramos na parte que pode garantir o seu futuro financeiro. Quando você sofre um acidente de trabalho na enfermagem, você entra em uma esfera de proteção jurídica que a maioria dos gestores odeia que você conheça.
Primeiro, entenda a diferença entre os benefícios do INSS. Se você se machuca em casa, recebe o B31 (auxílio-doença comum). Mas se o problema foi no hospital, você DEVE exigir o B91 (auxílio-doença acidentário). A diferença? O B91 te dá 12 meses de estabilidade quando você volta e obriga o hospital a continuar pagando seu FGTS enquanto você está em casa.
Mas a verdadeira “revelação” que eu prometi é a Pensão Vitalícia. Pouca gente sabe, mas se o acidente te deixar com uma sequela, mesmo que mínima (como a perda de sensibilidade em um dedo ou uma limitação de movimento), você pode ter direito a uma pensão paga mensalmente pela empresa pelo resto da sua vida. O Tribunal Superior do Trabalho (TST) tem decidido que, se houve redução da capacidade de trabalho, a indenização é devida. Imagine receber um valor mensal extra para compensar a limitação que o trabalho te impôs? Isso é justiça.
Comparativo de Benefícios: O que você ganha em cada caso
| Benefício | Sigla | Estabilidade | FGTS no Afastamento | Causa do Evento |
| Auxílio-Doença Comum | B31 | Não tem | Empresa para de pagar | Doença comum |
| Auxílio-Doença Acidentário | B91 | 12 meses após retorno | Empresa continua pagando | Acidente de Trabalho |
| Auxílio-Acidente | B94 | Indenizatória | N/A | Sequela permanente |
| Pensão Mensal Vitalícia | Art. 950 CC | Vitalícia (se couber) | N/A | Responsabilidade da Empresa |
Como tornar a informação sua maior aliada
Por exemplo, use a técnica do checklist para cada procedimento de risco. Não confie apenas na memória. O cansaço é o maior inimigo da precisão. Outro ponto: crie uma rede de apoio. Ter um grupo onde se discute segurança do trabalho não é “fofoca”, é sobrevivência coletiva. Ao compartilhar informações sobre protocolos de PEP e direitos à CAT, você está “hackeando” um sistema que muitas vezes lucra com a sua desinformação.
O que fazer se o hospital se recusar a emitir a CAT?
Se a empresa se recusar a emitir a Comunicação de Acidente de Trabalho (CAT), você não está de mãos atadas. Segundo a Lei 8.213/91, podem emitir o documento: o próprio trabalhador, seus dependentes, a entidade sindical competente, o médico que o assistiu ou qualquer autoridade pública. O registro pode ser feito de forma online no portal do Governo Federal.
O papel da tecnologia e o futuro da segurança ocupacional
Estamos entrando em uma era onde a inteligência artificial e os dispositivos vestíveis (wearables) podem prever quando um enfermeiro está prestes a sofrer um acidente por fadiga. Imagine um smartwatch que alerta o gestor de que sua frequência cardíaca e níveis de estresse indicam que você precisa de uma pausa imediata.
Até que isso seja realidade em todos os hospitais brasileiros, o “dispositivo” mais potente que você tem é o conhecimento. A educação permanente é o que separa o profissional que se torna uma estatística daquele que constrói uma carreira sólida e segura. Se você quer ser um enfermeiro de elite, precisa entender de biossegurança tanto quanto entende de farmacologia.
Não espere o acidente acontecer
Você não precisa ser a próxima vítima. O primeiro passo para a sua segurança é estar informado. Se você sentiu que este conteúdo abriu seus olhos, compartilhe-o agora com seu grupo de plantão. Salve este link, pois ele pode ser a diferença entre um afastamento sem direitos e uma recuperação com dignidade.
Conclusão
Chegamos ao fim dessa jornada e espero que você tenha percebido que o acidente de trabalho na enfermagem não é uma fatalidade inevitável, mas sim um evento que pode e deve ser prevenido com rigor técnico e consciência jurídica. Ao longo deste texto, exploramos desde as estatísticas alarmantes de 2025 até os direitos pouco conhecidos, como a pensão vitalícia e a estabilidade do B91.
Lembre-se: cuidar dos outros é a sua vocação, mas cuidar de si mesmo é a sua obrigação. O hospital é uma engrenagem que continua girando com ou sem você, mas para a sua família, você é insubstituível. Exija seus EPIs, denuncie irregularidades na NR-32 e nunca aceite que um acidente passe sem a devida notificação por meio da CAT. A sua saúde mental e física são o seu maior patrimônio. Não deixe que o acidente de trabalho na enfermagem defina o fim da sua história; use a informação para ser o autor de uma trajetória segura e de sucesso.
Perguntas frequentes
1. Sofri um acidente de trajeto indo para o hospital. É considerado acidente de trabalho?
Sim. O acidente ocorrido no percurso da residência para o trabalho ou vice-versa, independentemente do meio de locomoção, é equiparado ao acidente de trabalho para fins previdenciários e trabalhistas.
2. Posso ser demitido após voltar de um afastamento por acidente?
Se o seu afastamento foi superior a 15 dias e você recebeu o auxílio-doença acidentário (B91), você tem direito a 12 meses de estabilidade provisória. O hospital não pode te demitir sem justa causa nesse período.
3. O que acontece se eu não tomar o coquetel (PEP) após um acidente com agulha?
Você assume um risco altíssimo de soroconversão para HIV, Hepatite B ou C. A PEP reduz drasticamente as chances de infecção se iniciada rapidamente. Negligenciar a profilaxia pode ter consequências fatais ou gerar doenças crônicas incuráveis.
4. A empresa é obrigada a pagar meus medicamentos após o acidente?
Sim. Em caso de responsabilidade da empresa pelo acidente, ela deve arcar com todos os danos materiais, o que inclui consultas, exames, medicamentos e tratamentos necessários para sua plena recuperação.
5. Burnout dá direito a indenização?
Sim, se ficar comprovado por perícia médica que a síndrome foi causada ou agravada pelas condições de trabalho (nexo causal ou concausal), o trabalhador tem direito a indenização por danos morais e materiais, além da estabilidade acidentária.
Quais são os 3 tipos principais de acidentes de trabalho?
Os tipos de acidente de trabalho incluem típico (ocorre durante a execução das atividades laborais), de trajeto (no percurso entre casa e trabalho) e doença ocupacional (decorrente das condições do ambiente laboral).
O que é a NR 32 na enfermagem?
É uma legislação do Ministério do Trabalho e Emprego que estabelece medidas para proteger a segurança e a saúde dos trabalhadores de saúde em qualquer serviço de saúde inclusive os que trabalham nas escolas, ensinando ou pesquisando.
Qual o prazo para informar acidente de trabalho?
O acidente de trabalho deve ser comunicado à Previdência Social até o primeiro dia útil seguinte ao da ocorrência e, em caso de morte, de imediato, à autoridade competente, sob pena de multa.
Vocês atendem clientes de outros estados de forma online?
Sim, nosso atendimento é 100% digital e abrange todo o território nacional. Graças ao uso de certificados digitais e processos eletrônicos, conseguimos realizar reuniões, coletar assinaturas e protocolar ações em qualquer tribunal do Brasil sem a necessidade de contato físico. Isso garante mais agilidade e segurança para resolver o seu caso, onde quer que você esteja.
É legal obrigar funcionário a participar de reunião fora do horário de trabalho sem pagar hora extra
O empregador não tem o direito de obrigar o funcionário a participar de reuniões fora…
Doenças do trabalho e seus direitos
Você sabia que uma lesão adquirida na empresa pode garantir seus direitos? Quando falamos de…
Direitos do trabalhador home office
Você já sentiu que, desde que começou a trabalhar de casa, a sua sala virou…
Atraso salarial e FGTS não depositado
Você acorda cedo, pega ônibus lotado, cumpre metas, engole sapos e, no quinto dia útil,…
Geolocalização no direito trabalhista
Você já se sentiu de mãos atadas em uma audiência por não conseguir provar o…
Fui demitido do banco: 5 direitos que você não conhece
Sabe aquele frio na espinha quando você é chamado para uma “reunião rápida” e percebe…




